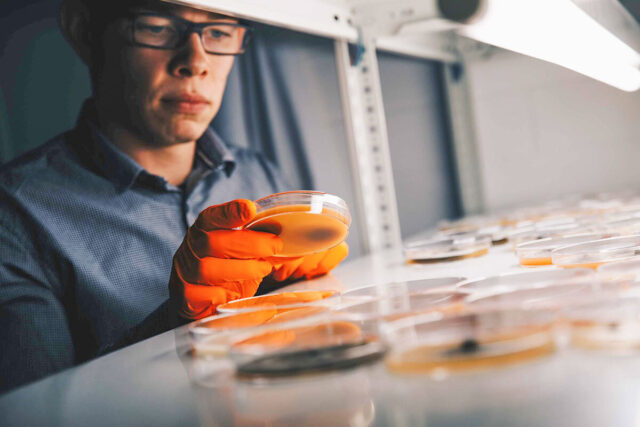

Grüne Berufe
Spaß am Wachsen und Gedeihen
Wer die grünen Berufe bei KWS in Einbeck erlernt, erlebt die ganze Bandbreite: Feld, Gewächshaus und Labor. Agrarwirtschaftlich-technischer Assistent und Pflanzentechnologin: Luca Scholz und Emelie Niemeier berichten von ihrer Traumausbildung bei KWS.
Luca Scholz: zielstrebig zum Wunschberuf
Mit der Berufsbezeichnung Agrarwirtschaftlich-technischer Assistent (ATA) hätte Luca Scholz im Alter von acht Jahren nichts anfangen können. Aber eines wusste der gebürtige Niedersachse bereits als Grundschüler: „Wenn ich groß bin, möchte ich dafür sorgen, dass Pflanzen wachsen und gedeihen.“ Und es sieht so aus, als ginge sein Wunsch tatsächlich in Erfüllung. Seit Sommer 2018 macht Luca Scholz bei KWS in Einbeck eine Ausbildung zum ATA.
Kaum hatte er seinen erweiterten Realschulabschluss in der Tasche, trat er ein vierwöchiges Schnupperpraktikum bei KWS an. Direkt danach begann seine Ausbildung. Zunächst besuchte der 18-Jährige ein halbes Jahr lang die Berufsbildende Schule (BBS) Einbeck, es folgte ein einjähriges Fachpraktikum in seiner Stammabteilung, der Phytopathologie, die sich mit Pflanzenkrankheiten befasst. Diese praktische Phase ist nun beendet. Der junge Mann steckt seine Nase in die Bücher, denn Ende Mai beginnen die Klausuren. Pflanzenbau, Chemie, Züchtung, Versuchswesen, Mathematik. Die Prüfungen sind anspruchsvoll.
„Mit KWS Saatgut kam ich bereits als kleiner Junge in Kontakt“
Luca Scholz
Kindheitstraum KWS
Als Kind verbrachte Luca Scholz jede freie Minute auf einem Bauernhof in der Nachbarschaft. Bis heute verbindet ihn eine tiefe Freundschaft mit dem Landwirt, der Zuckerrüben, Raps und Weizen anbaute. Das Wetter spüren, den Boden riechen, Trecker fahren, ordentlich zupacken und nach getaner Arbeit zusammen den Tag Revue passieren lassen – das hat Luca Scholz immer geliebt. KWS kannte er lange, bevor er sich bewarb. „Mit KWS Saatgut kam ich bereits als kleiner Junge in Kontakt“, berichtet er.
Selbst Bauer zu werden, kam für ihn nicht in Frage, aber er verbringt immer noch viel Zeit auf dem Hof seines Freundes. „Die Nähe passt zu meiner Ausbildung. Ich verstehe Landwirte.“
Während seines einjährigen Fachpraktikums hat der Alfelder im Rahmen von Ausbildungsveranstaltungen viele Arbeitsbereiche bei KWS kennengelernt – so die Saatgutproduktion, den Zellservice, die Molekularbiologie, Labore und Züchtungsabteilungen. Doch auch, wenn er sämtliche Stationen bereichernd fand, sein Herz schlägt für die Phytopathologie, für die Analyse von Schädlingen, Resistenztests, phytopathologische Untersuchungen. Felder und Gewächshäuser sind ebenso sein Arbeitsplatz wie Labor und Büro. „Ich bin hier sehr glücklich“, schwärmt der junge Mann, der in seiner Freizeit angelt und sich bei der Freiwilligen Feuerwehr engagiert.
Wenn die Klausuren im Mai gelingen, winkt ein befristeter Arbeitsvertrag bei KWS.
Emelie Niemeier: Lieblingsfach Biologie
Auch Emelie Niemeier ist auf dem besten Weg zu ihrem Wunschberuf. Bereits zu Schulzeiten wollte sie in einem Labor mit Pflanzen arbeiten. „Die Vorstellung fand ich mega“, erzählt die heute 19-Jährige, die seit August 2017 eine duale Ausbildung zur Pflanzentechnologin bei KWS absolviert. Mädchen für naturwissenschaftliche Inhalte begeistern – diesen Appell hat sie nicht gebraucht. Biologie war ihr Lieblingsfach.
Emelie Niemeier machte an der Oberschule Delligsen im Landkreis Holzminden, Niedersachsen, ihren Realschulabschluss. Auf KWS wurde sie in der achten Klasse aufmerksam. Eine Mitschülerin hatte nach einem Betriebspraktikum das Unternehmen vorgestellt. „Ich habe mich sofort im Internet informiert und bin auf den Beruf des Pflanzentechnologen gestoßen“, erinnert sich Emelie Niemeier.
„Im Labor zu arbeiten, ist noch viel cooler, als ich dachte“
Emelie Niemeier
Zugehörig und wertgeschätzt
Inzwischen ist das Berufsbild für sie weit mehr als eine abstrakte Beschreibung. Im Kulturlabor hat sie bereits Zuckerrüben, Raps und Weizen gesät, vermehrt und geerntet und im Untersuchungslabor gelernt, was Eluieren ist. Bei diesem Verfahren trennen Pflanzentechnologen mit Pinzette und Skalpell die DNA von der feinen Pflanzenmembran. Fingerfertigkeit ist gefragt. Emelie Niemeier ist in ihrem Element. „Im Labor zu arbeiten, ist noch viel cooler, als ich dachte – größer, professioneller, einfach beeindruckend.“
In der dualen Ausbildung wechseln sich Blockunterricht und Fachpraxis ab. Gewächshaus, Zuchtgarten und Feld gehören ebenso dazu wie Saatgutwesen, Büro und Labor. Auf mindestens zwei Gebieten werden die Auszubildenden eingesetzt. Analysemethoden, Untersuchungsreihen, die Entwicklung und Züchtung neuer Sorten, die Arbeit an der Sterilbank – es sind nicht nur die Ausbildungsinhalte, die Emelie Niemeier, die in ihrer Freizeit Fußball spielt, so mag. Es sind auch ihre Kollegen. „Ich fühle mich zugehörig. Von Anfang an sind mir meine Kollegen auf Augenhöhe und sehr wertschätzend begegnet“, betont sie.
Ausbildungsleiter fördern Teamgeist
Alle Fäden der Ausbildung in den grünen Berufen laufen bei Berthold Niehoff, Doris Engelhardt und Linda Märzke zusammen. Von den Bewerbungseingängen bis zu den Abschlussprüfungen ihrer Schützlinge übernehmen der Ausbildungsleiter und seine Stellvertreterinnen alle organisatorischen Aufgaben. Jedes Jahr bildet KWS achtzehn ATA sowie elf Pflanzentechnologen aus. Dazu kommen rund zwanzig Schüler, die ein Praktikum absolvieren und in verschiedene Bereiche reinschnuppern. Auch am Zukunftstag, der Schülern eine erste Berufsorientierung ermöglicht, beteiligen sich die Ausbildungsexperten.
„Unsere Ausbilder sind kompetent und engagiert. Sie machen einen tollen Job.“
Berthold Niehoff
Und: Berthold Niehoff, Doris Engelhardt und Linda Märzke sind Ansprechpartner für das Zwischenmenschliche. „Uns ist der Teamspirit sehr wichtig. Wir wollen das Gemeinschaftsgefühl stärken, denn die Azubis sollen sich bei uns wohlfühlen“, sagt Linda Märzke, die als ATA einen Großteil ihrer Arbeitszeit in der Maiszüchtung verbringt. So gibt es unter anderem Einführungstage für alle und ein Teamseminar mit Übernachtung, damit sich die Nachwuchs KWS’ler kennen lernen und austauschen. „Für den Zusammenhalt sind die Ausbilder vor Ort von zentraler Bedeutung“, weiß Doris Engelhardt, und ihr Vorgesetzter Berthold Niehoff bestätigt: „KWS Ausbilder sind kompetent und engagiert. Sie machen einen tollen Job.“ |
IN KÜRZE
Daten, Zahlen, Fakten
Agrarwirtschaftlich-technischer Assistent (ATA):
- Zweijährige Ausbildung
- Ausbildungsverlauf: 6 Monate Berufsschule (BBS Einbeck) in Vollzeit, 12 Monate fachpraktisches Jahr bei KWS, 6 Monate Berufsschule (BBS Einbeck) in Vollzeit
- Arbeitsorte: Freiland, Gewächshaus, Labor, Büro
- Ausbildungsinhalte: Zuchtgarten, Versuchsbetreuung und -dokumentation, analytische Chemie, Biotechnologie, Kulturlabor, Phytopathologie und Qualitätsbestimmung
- Voraussetzung: Realschulabschluss
Pflanzentechnologie:
- Dreijährige duale Ausbildung
- Pro Lehrjahr je 11 Wochen Berufsschule (BBS Einbeck), in drei bis vierwöchigen Blöcken und im Wechsel mit der Fachpraxis bei KWS
- Die BBS Einbeck ist die einzige Schule bundesweit, die Pflanzentechnologen unterrichtet. Die Schüler kommen aus ganz Deutschland.
- Arbeitsorte: Feld, Gewächshaus, Kulturlabor, Saatgutwesen, Untersuchungslabor, Zuchtgarten
- Ausbildungsinhalte: Pflanzen anbauen, pflegen und ernten, Pflanzen kultivieren sowie untersuchen
- Voraussetzung: guter Hauptschulabschluss oder Realschulabschluss |
Kontakt:
Doris Engelhardt
doris.engelhardt@kws.com
Linda Märzke
linda.maerzke@kws.com
Berthold Niehoff
berthold.niehoff@kws.com
© KWS SAAT SE & Co. KGaA 2026